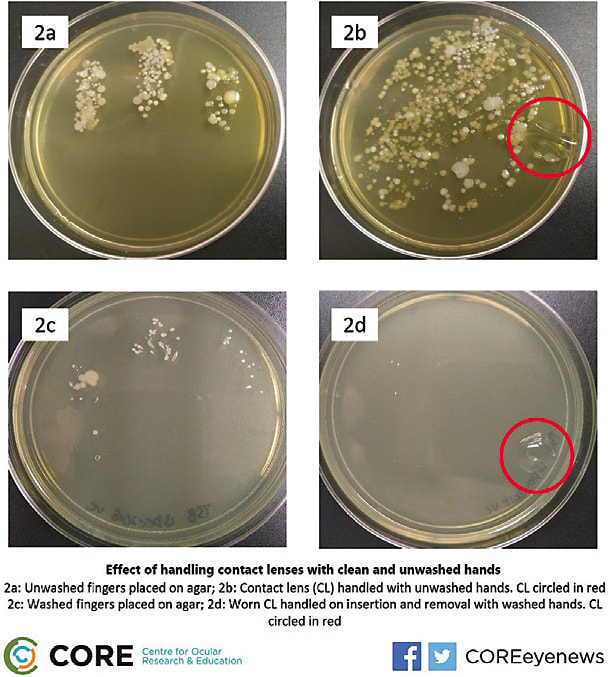
Remember to tag @COREeyenews in your post to provide attribution.

These resources can help boost your online presence
Share Studies

SIX IN 10 AMERICAN ADULTS report digital eye strain symptoms
80% OF ADULTS use digital devices for more than two hours a day
(STATISTICS COURTESY OF THE VISION COUNCIL)
→ Consider adding the image and data above to your posts.
BY SHARING timely study information on your social media platforms, you can engage patients, and help them take a more active role in their health care. Be sure to present information in a language your patients can understand. For example, consider this script:
“DIGITAL EYE STRAIN is the discomfort that comes from an accumulation of hours on a screen, be it a laptop, cell phone, etc. Symptoms for adults include neck and shoulder pain, headaches and blurred vision; for kids they are similar but can also include reduced attention span and irritability, according to The Vision Council. While limiting screen usage is an option for some, it’s an inevitability for others. Whichever camp you’re in, our office can help! Give us a call to make an appointment to discuss your needs.”
Facebook Live Promotion:
AMD/Low Vision Awareness Month
ACCORDING TO PREVENT BLINDNESS (see bit.ly/2M7lrwT ), February is AMD/Low Vision Awareness month. To expand awareness, consider a Facebook Live streaming video with relevant talking points, for example: “AMD is a leading cause of vision loss, affecting more than 2 million Americans age 50 and older. Common symptoms include blurred and wavy central vision, even a blind spot. The good news: AMD can be managed with the help of an eye care professional. Give our office a call today, and protect your vision.” (Include your phone number and/or contact us page in the post.)
Also consider a Facebook Live video to promote low vision awareness.
NEW TO FACEBOOK LIVE? To find out more, see https://bit.ly/2CjYH8l .

Contact Lens Care
→ Another option for a Facebook post:
HYGIENIC CONTACT LENS CARE requires a few steps but, ultimately, supports your overall eye health. Researchers from the Centre for Ocular Research & Education at the University of Waterloo examined the effect of handling contact lenses with washed and unwashed hands. The results? Significantly higher amounts of bacteria, as seen right.
BOTTOM LINE: Take the extra step; thoroughly wash your hands. Your eyesight is too important.
Hashtags in February
→ Use hashtags to connect online with those who share a common interest.
#SuperBowl Feb. 3
In 2017, #football accounted for an estimated 1,448 eye injuries, according to Prevent Blindness. It’s recommended that athletes have a polycarbonate shield attached to the faceguard to prevent such injuries.
#NewYorkFashionWeek Feb. 7 to 15
Eye Spy! Tag us in photos of your celebrity favorites who are sporting their eyewear both on the runway and in the audience.
→ IMAGE DOWNLOAD LINK
bit.ly/OMtoolkit
All corresponding images are available to download and use for free.



